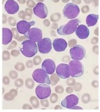
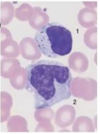

Características de la BH
- Se considera como 1 solo examen de laboratorio
- Valora 3 líneas celulares de funciones diferentes
- Todas producidas en la médula ósea
g/dL
Valores normales de la hemoglobina
Hombre y mujer
- Hombre: 15.5 - 13.5
- Mujer: 14 - 12
Más de dos desviaciones estandar de diferencia es patológico
%
Valores normales del hematocrito
Hombre y mujer
- Mujer: 41- 36
- Hombre: 47 - 41
Más de dos desviaciones estandar de diferencia es patológico
Valores normales de la cuenta de globulos rojos
Hombre y mujer
- Mujer: 4.6 - 4.0
- Hombre:5.2 - 4.5
Más de dos desviaciones estandar de diferencia es patológico
fL
Valores normales de MCV
90 - 80
pg
Valores normales de MCH
30 - 26
g/dL
Valores normales de MCHC
34 - 31
Diferencias entre BH y Frotis
- BH: cantidad de células, estudia si la médula ósea produce una cantidad suficiente de células madre
- Frotis: morfología de las células, si el desarrollo de las células hematopoyéticas es cualitativamente normal

Compone la determinación de los índices eritrocitarios primarios y secundarios
Serie roja
¿Cuales son los indices eritrocitarios primarios y a partir de que se determinan?
-Hb, Hto, eritrocitos
Se determinan directamente a partir de la muestra de sangre total del p
Los índices eritrocitarios primarios son….
Cuantitativos: normalidad, anemia o policitemia
¿Cuales son los índices eritrocitarios secundarios?
4
- Volumen corpuscular medio (VCM)
- Hemoglobina corpuscular media (HCM)
- Concentración media de la Hb corpuscular (CMHC)
- Ancho de distribución eritrocitaria (ADE)

Como se calcula y que indica el VCM
- Indica microcitosis o macrocitosis
Hematocrito (L/L) / Eritrocitos (x10*12 /L)
¿Qué indica y como se calcula la HCM?
- Indica si ay hipercromía o hipocromía
Hemoglobina (g/L) / Eritrocitos (x10*12 /L)
¿Qué indica y como se mide la CMHC?
- Indica el tamaño y contenido de la Hb en la población de eritrocitos estudiados
Hemoglobina (g/L) / Hematocrito (L/L)
¿Qué indica el ADE?
Indica el espacio entre cada eritrocito (simetria) e indicaría si todos tienen la misma morfología o si son irregulares
Anisocitosis
Tamaño muy distinto entre eritrocitos
Precursor de eritrocito maduro
Reticulocitos
Antes de perder el núcleo
¿Qué se puede valorar a traves de la presencia de reticulocitos en serie roja?
Valoración de la producción de eritrocitos en la médula ósea
¿Cuando pasan los eritroblastos a reticulocitos?
Cuando los eritroblastos se liberan del núcleo se transorman en reticulocitos y se liberan en la sangre periférica
¿Cuanto tiempo tardan en convertirse en eritrocitos maduros?
Reticulocitos
48 horas
Niveles normales de reticulocitos en serie roja
Del 1 al 2%
¿Que significa la presencia de reticulocitos o eritroblastos en frotis sanguínea?
Indica la compensación de alguna otra patología en el cuerpo

Los reticulocitos nos permiten clasificar el tipo de anemia desde 2 puntos fisiopatológicos
- Arregenerativa: no tiene la capacidad de regenerar lo que está perdiendo
- Regenerativa: envia células, aunque sea reticulocitos